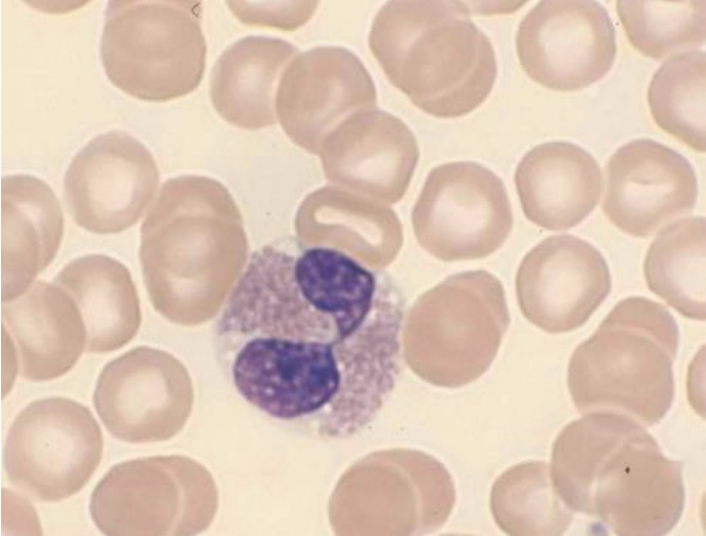
term image
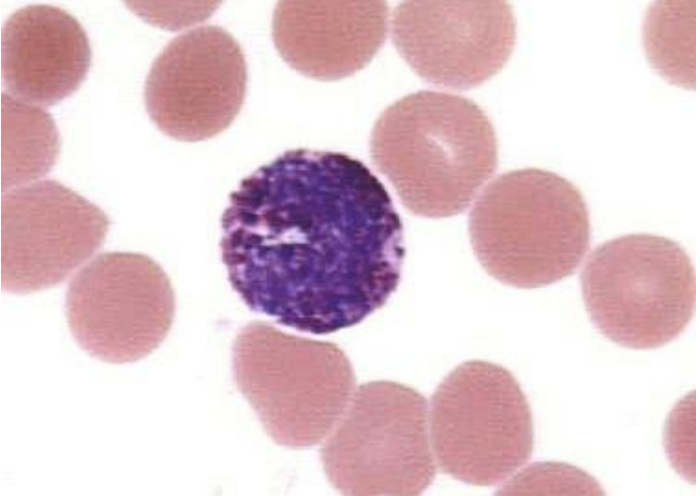
term image
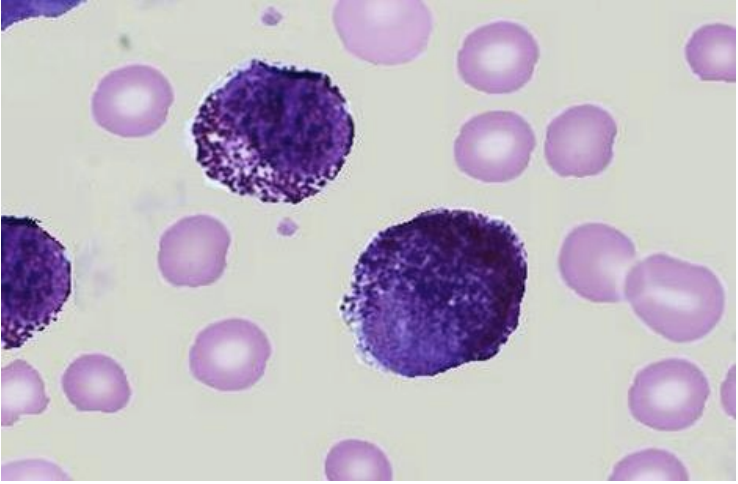
term image
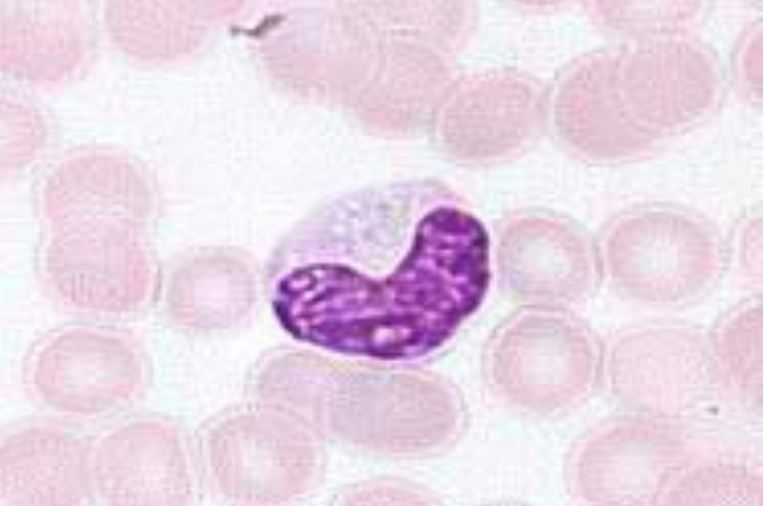
term image
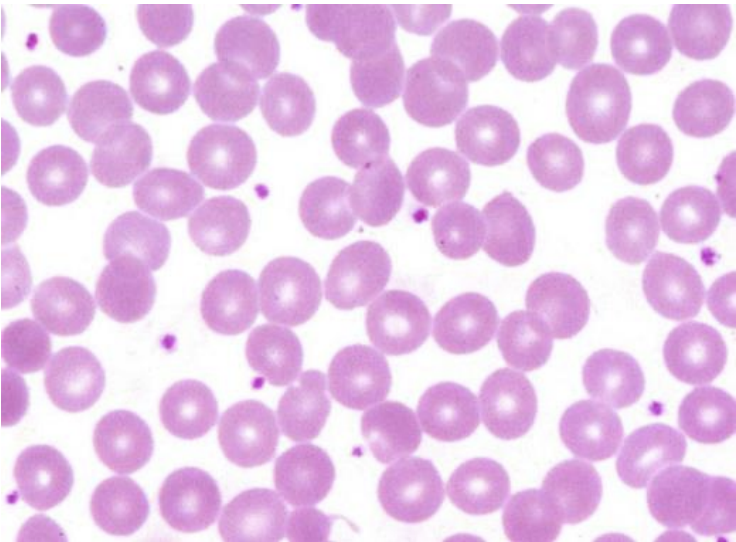
term image
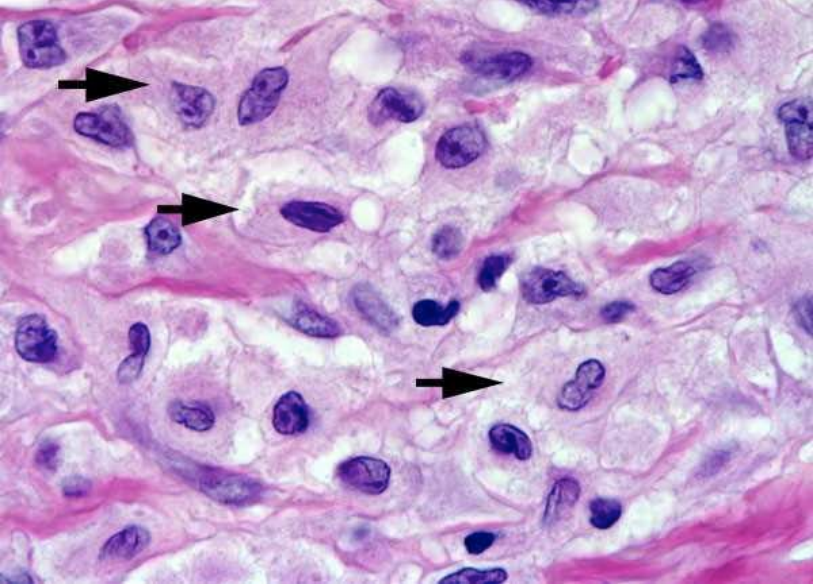
term image

1/23
Looks like no tags are added yet.
Name | Mastery | Learn | Test | Matching | Spaced | Call with Kai |
|---|
No analytics yet
Send a link to your students to track their progress

Blood Vessel
Tunica Adventitia/Tunica Externa
outer layer
made up of elastic and type I collagen connective tissue
Tunica Media
middle layer
made up of smooth muscle
responsible for vasoconstriction and vasodilation in order to
regulate peripheral blood pressure
Tunica Intima
inner layer
made up of endothelial cells

Neutrophil
Eosinophil
Basophil
Mast Cell
Monocyte

Epithelioid Macrophages

Langhans

Foreign Body

Touton
Platelets

Von Kupffer Cell

Alveolar Macrophages
Histiocyte

Peyers Patches

Mesangial Cell

Enterolith

Cholelith

Cystolith

Gastrolith

Nephrolith

Urolith (ammonium urates)

arrows point to abnormal aggregates of protein that develop inside nerve cells in Parkinson's disease and certain other neurodegenerative disorders
Brain Tissue
arrows: Lewy bodies

Siaolith